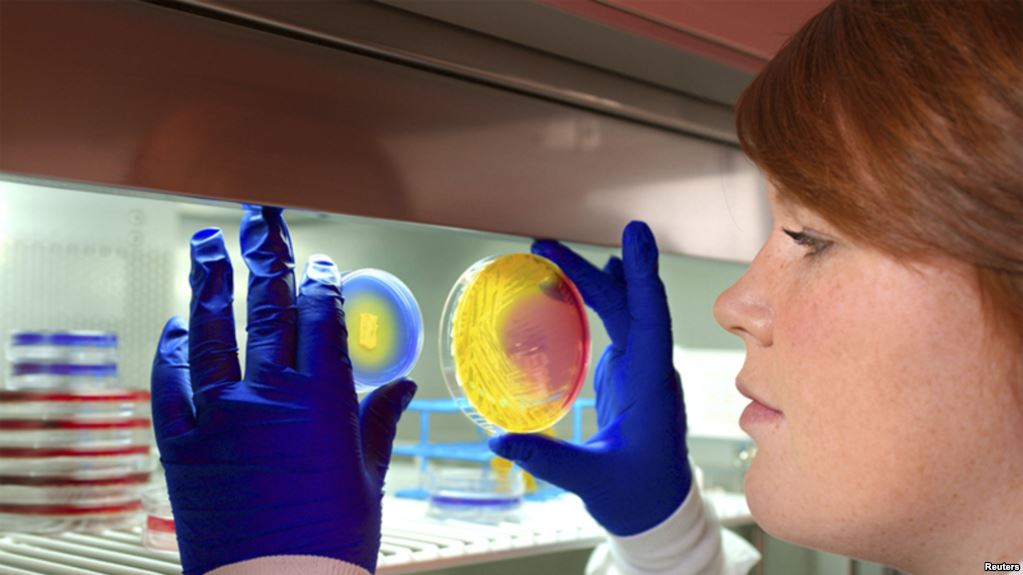

Organismos internacionales vuelven a encender las alarmas acerca del uso de antibióticos.
¿Por qué? ¿Qué está pasando y cuáles podrían ser los efectos del uso indiscriminado de este tipo de fármacos?
Desde el 2015 que la Organización Mundial de la Salud está alertando sobre el abuso de los antibióticos. Una advertencia que se repite desde entonces cada noviembre en la Semana Mundial de Concientización sobre el uso de estos fármacos.
Expertos en salud aseguran que lo que hasta ahora ha sido la piedra angular de la medicina moderna, podría en algunos años, convertirnos en víctimas de nuevas y de ya conocidas enfermedades.
Según un estudio de la Organización para la Cooperación y el Desarrollo Económico, el efecto de esta situación podría ser tan grave que para el 2050 morirían más personas por la resistencia antimicrobiana que a causa del cáncer.
Te puede interesar: Ciencia en Primera Persona: ¿Cómo enfrentar la amenaza de las “superbacterias”?
2,4 millones de personas podrían morir sólo en Europa, América del Norte y Australia, aunque tres de cada cuatro muertes podrían evitarse destinando dos dólares por persona al año en medidas tan simples como el lavado de manos y prescripciones racionales de medicamentos de parte de los médicos.
Por todo lo anterior, no consumir medicamentos sin receta es una de las medidas fundamentales para frenar estos efectos que en Chile, estarían siendo visibles desde hace al menos tres años y para el que se han diseñado protocolos de aislamiento de pacientes.
Entre las alternativas se propone eliminar los antibióticos en la ganadería y la agricultura, donde son utilizados para tratar infecciones y para que los animales crezcan más y más rápido, algo que en contacto con las personas también aumenta la posibilidad de desarrollar resistencia antimicrobiana.
Al respecto en Un Nuevo Día de CNN Chile conversamos con el secretario general del Colegio Médico de Chile, José Miguel Bernucci, quien comentó que el uso indiscriminado de antibióticos ha generado que aparezcan cepas resistentes que generan una dificultad tremenda en el tratamiento de pacientes, encarecimiento en costos de atención y un aumento de la morbilidad y mortalidad asociadas a enfermedades que se creían controladas.
Te puede interesar: Las precauciones ante la resistencia de las bacterias a los antibióticos
“Han aparecido enterobacterias que son multiresistentes a todos los antibióticos que ya hemos conocidos, afectan principalmente a pacientes que están en la UCI, UTI o que han sido sometidos a cirugías o procedimientos invasivos”, explicó Bernucci.
Mira la entrevista completa en el video adjunto.
Lo más leído
- Caso Codelco: Cámara de Diputados inicia comisión investigadora por presuntos abultamientos en producción de cobre de la minera estatal
- PAES de Invierno 2026: ¿Cuándo se publican los resultados?
- Gobierno anunció entrega de fondo de $2.520 millones a ferias libres: ¿Cómo postular al programa?
- Buscan trabajadores para faena minera en Calama: Revisa los cargos disponibles en El Abra
- Alejandro Sepúlveda recuerda a Abraham Santibáñez: “Tuve la suerte de ser su ayudante en la universidad durante varios años”







